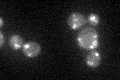
YJL207C
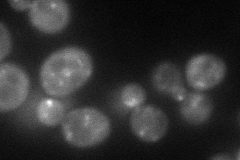
YJL207C
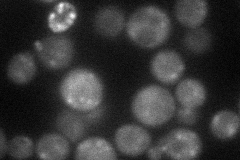
YJL207C
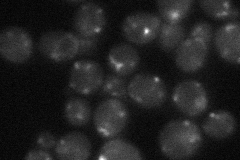
YJL207C
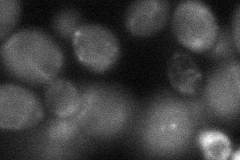
YJL207C
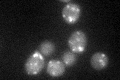
YJL207C
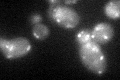
YJL207C
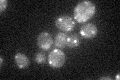
YJL207C

View description
AP-1 accessory protein; colocalizes with clathrin to the late-Golgi apparatus; involved in TGN-endosome transport; physically interacts with AP-1; similar to the mammalian p200; may interact with ribosomes; YJL207C is a non-essential gene
Localization:
Intensity:
Fold change:
Significance:
-
C’ GFP library in SD
punctate36.03 -
N' NOP1pr-GFP in SD
punctate56.2516 -
N' TEF2pr-mCherry in SD
punctate36.7023 -
N' NATIVEpr-GFP in SD
punctate31.3485 -
N' TEF2pr-VC and Cyto-VN in SD
cytosol,punctate36.5442 -
C’ GFP library in SD+DTT
punctate32.790.91No -
C’ GFP library in SD+H2O2
punctate38.351.06No -
C’ GFP library in Starvation Media
punctate32.080.89No -
C’ GFP library on the background of Pup2-DaMP

punctate -
C’ GFP library on the background of CCT mutant

punctate38.39871.06563No
